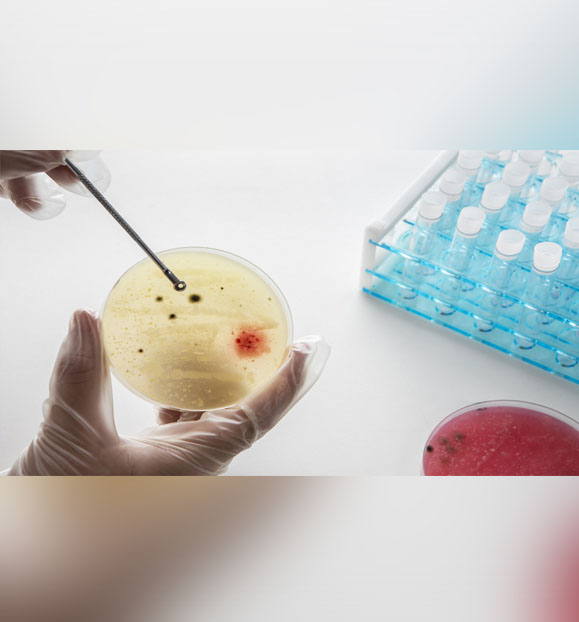

From the Dean's Desk October-2025

Prof. Upendra V. Bhandarkar
Dean – Alumni and Corporate Relations
Professor, Department of Mechanical Engineering
IIT Bombay

Dear Alumni,
Last month, I had the privilege of writing to you for the first time as Dean of Alumni and Corporate Relations. The warm responses and encouragement I received from many of you were deeply heartening, and they reaffirmed the strength of the IIT Bombay alumni community. It is with that same sense of connection and purpose that I now write to you again, in this October 2025 edition of our newsletter. Our alma mater has been abuzz with activity, with our faculty, students, and alumni making their mark across diverse fronts. I am pleased to share a few highlights from the past weeks that showcase the energy, innovation, and impact that continue to define IIT Bombay.
To begin with, I am delighted to share the Dean ACR Annual Report 2024–25, which is a snapshot of the year gone by and includes our milestones, partnerships, and the many ways the support of alumni, corporate partners, and well wishers has helped IIT Bombay grow. I encourage you to take a look and download the report to see the impact you’ve helped create. As we move forward, we’re also inviting you to give back through the Young Faculty Fund (YFF), an initiative that enables bright young academicians to pursue cutting-edge research at IIT Bombay. Your support can help nurture the next generation of thinkers and innovators who will carry our legacy forward.
Dean ACR Annual Report
2024-25
Dean ACR Annual Report
2024-25
LEGACY OF EXCELLENCE
NIRF Rankings
SPECIAL REPORT
GIVING BACK
Young Faculty Fellowship
ALUMNI GIVING

• Ajit Dubhashi
CORPORATE COLLABORATION
• HDFC ERGO
FACULTY SPOTLIGHT
• Prof. Ganesh Ramakrishnan
• Prof. Pushpak Bhattacharyya
• Prof. Dhimant Vyas
• Prof. Swati Agarwal
ALUMNI SPOTLIGHT
• Kshitij Jayakrishnan
• Mitesh Khapra
ALUMNI STARTUP SPOTLIGHT
• Rifa AI
• Manastu Space
• Parallel Web Systems
• Upliance 2.0
IITB CENTRES OF EXCELLENCE
• KCDH
• SINE IIT Bombay
• IIT Bombay
• ASPIRE IITB Research Park Foundation
• C-MInDS
RESEARCH SPOTLIGHT
• Microbes Hint at Evolution’s Unsolved Question
• Could the Cold, Dark Oceans Cool our Data Centres?
• Mathematical Model to Test Traffic Control Algorithms
• New Model Decodes Earth Images With Natural Language
STUDENT-FACULTY RESEARCH COLLABORATION

• IITB’s Flood Forecasting Supports Mumbai During Rains
STUDENT SUCCESS STORY
• IITB students Map Lunar Chemistry
• IITB Students Top Global Motorsport Stage